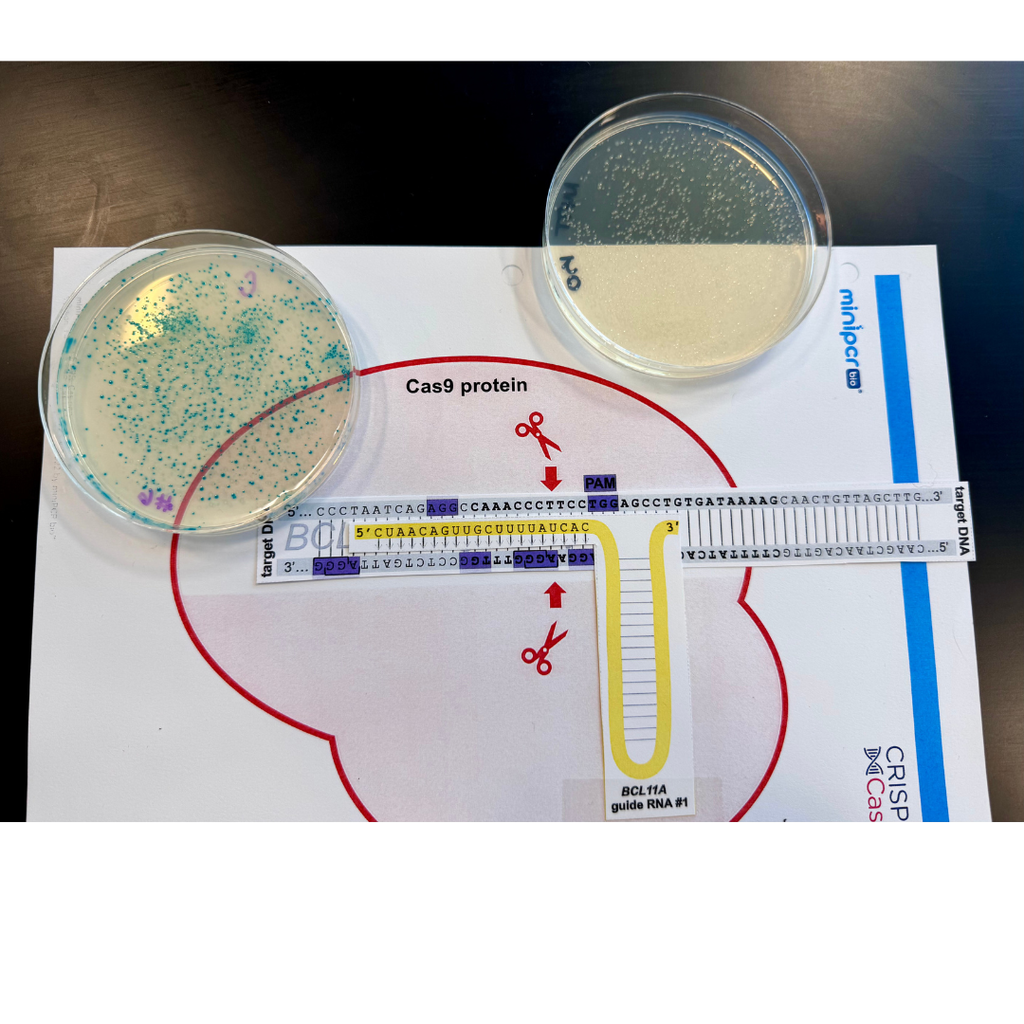
apply CRISPR gene-editing technology to modify a bacterial genome by knocking out a bacterial gene

Beginners and pros came together to stitch, chill, and enjoy some cozy Valentine’s vibes with yarn and friends this week for Crochet and Knit Club!


Masa Alkhudari was nominated for Northwest PA C.L.A.S.S. Act Emerging Leader by Mrs. Groff.

Erie Experience classes began the semester making posters of things that "represent" Erie to them. Ideas ranged from the Erie Otters, to Asbury Woods, to snow storms, to the Warner walleye fishing, and more!





Twelve Fairview students participated in the Columbia Model United Nations Conference & Exposition, visited the United Nations Headquarters and met with the permanent representative of Jordan to the UN. Ayush Bharath received Honorable Mention (Third Place) in his committee.



Students at FHS had the opportunity for some extra pets and fun from Maggie and Evie's friends at Therapy Dogs United! Even Mr. Greene's Poppy came in to provide support for students!







Students in the RMU Statistics course completed a project at the end of the course putting into practice what they learned. The topics they chose to do covered many different subjects. Just to name a few: Vulgarities in social media past vs present, drive thru wait times vs walk in at local restaurants, throwing distance before and after watching a teaching technique video and lunch item availability of A lunch vs C lunch. Students do a completed study on their topic from planning to data collection to statistical analysis to conclusions. Pictured below is data collection in action of comparing vertical jumps of our different sports teams. Also studying if restaurant tipping is done more by cash or card.





Mrs. Nelson’s 9th graders created final project presentations that included sing alongs, live music, interactive games, team activities, and spectacular visual slides!





Mrs. Heitzenrater's SAT/ACT Prep class is taking their final SAT practice test.


Four FHS Choir students attended the PMEA District 2 Choir festival on January 7-9, 2026 at Allegheny College. Jailyn Bull, Jabin Bull, Amelia D'Silva and Emily Strazisar represented Fairview in the Soprano and Bass sections. Jailyn and Jabin have advanced to the PMEA Region Choir festival which will take place in DuBois, PA from February 19-21, 2026.

For their final project, Miss Nelson’s English 10 students played Dungeons and Dragons. Students used their knowledge of characterization to design characters who embarked on an adventure created by a special guest DM and FHS alumnus Sulley Nelson. Throughout this adventure, students encountered familiar faces and themes from this the course while engaging in collaborative problem-solving.





The 12 principles of animation are guiding the FHS students while they develop their stop motion animations about “Play Stories”.





Fairview High School hosted the Career Cafe, a lunchtime event highlighting future occupations for students. The Health & Science Academy sponsored a session on veterinary science featuring Dr. Curt Murphey and veterinary student Abby McCall. The Arts & Communication Academy offered a presentation on architectural design featuring Katie Osinski of the Reveal Design Group in New York City.


'Twas the week before Christmas, and "Ski Bums Day" at FHS. So naturally the students wanted to dance to Pigloo's "Moi. j'aime skier"!
On December 15 the French Club held their annual holiday celebration. Of course, crêpes were the highlight!
The Law class was treated to a co-presentation this week from Attorney Pagliari and Magisterial District Judge Scarpitti. The speakers brought to life the trial process, walked the students through a typical pre-trial proceeding and answered questions about the local issues they deal with daily.



More presentations for Wellness 10 who have been learning about the body systems and setting records in the weight room.







Wellness 10 has been learning about the body systems and setting records in the weight room!



Vivian Liu was nominated for Northwest PA C.L.A.S.S. Act Emerging Leader by Mr. Fennell and Mr. Greene.

Seniors Ulyana Hoja and Anna Buhl apply CRISPR gene-editing technology to modify a bacterial genome by knocking out a bacterial gene. Ulyana carefully micropipettes the transformed bacterial culture onto agar plates while Anna evenly spreads the sample to ensure consistent growth. Their results highlight successful gene editing, with unedited blue colonies visible on the right and edited white colonies on the left.

Students in Miss Ramsay's Theater Studies class are making simple adaptations of Bunraku puppets. Though not as intricately designed as in Japanese theater, the puppets allow students to practice with moving and breathing as one. Each puppet is controlled by three students and they are challenged with making the movement look natural. They say it's quite the workout! The puppets will ultimately be used in scenes they will perform at the end of the week.





